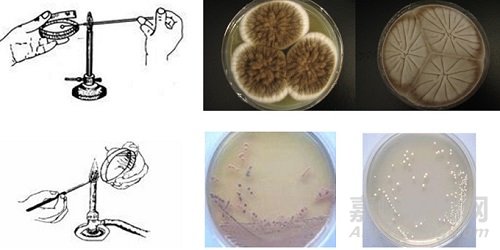

您當前的位置:檢測資訊 > 科研開發
嘉峪檢測網 2021-09-10 20:27
正文:
1、最常用的接種方法。即在固體培養基表面作來回直線形的移動,就可達到接種的作用。常用的接種工具有接種環,接種針等。在斜面接種和平板劃線中就常用此法。
2、三點接種
在研究霉菌形態時常用此法。此法即把少量的微生物接種在平板表面上,成等邊三角形的三點,讓它各自獨立形成菌落后,來觀察、研究它們的形態。除三點外,也有一點或多點進行接種的。
3、穿刺接種
在保藏厭氧菌種或研究微生物的動力時常采用此法。做穿刺接種時,用的接種工具是接種針。用的培養基一般是半固體培養基。它的做法是:用接種針蘸取少量的菌種,沿半固體培養基中心向管底作直線穿刺,如某細菌具有鞭毛而能運動,則在穿刺線周圍能夠生長。

4、澆混接種
該法是將待接的微生物先放入培養皿中,然后再倒入冷卻至45℃左右的固體培養基,迅速輕輕搖勻,這樣菌液就達到稀釋的目的。待平板凝固之后,置合適溫度下培養,就可長出單個的微生物菌落。
5、涂布接種
與澆混接種略有不同,就是先倒好平板,讓其凝固,然后再將菌液倒入平板上面,迅速用涂布棒在表面作來回左右的涂布,讓菌液均勻分布,就可長出單個的微生物的菌落。

6、液體接種
從固體培養基中將菌洗下,倒入液體培養基中,或者從液體培養物中,用移液管將菌液接至液體培養基中,或從液體培養物中將菌液移至固體培養基中,都可稱為液體接種。

7、注射接種
該法是用注射的方法將待接的微生物轉接至活的生物體內,如人或其它動物中,常見的疫苗預防接種,就是用注射接種,接入人體,來預防某些疾病。
8、活體接種
活體接種是專門用于培養病毒或其它病原微生物的一種方法,因為病毒必須接種于活的生物體內才能生長繁殖。所用的活體可以是整個動物;也可以是某個離體活組織,例如猴腎等;也可以是發育的雞胚。接種的方式是注射,也可以是拌料喂養。
注:有所接種必須無菌操作
培養基經高壓滅菌后,用經過滅菌的工具(如接種針和吸管等)在無菌條件下接種含菌材料(如樣品、菌苔或菌懸液等)于培養基上,這個過程叫做無菌接種操作。在實驗室檢驗中的各種接種必須是無菌操作。
①接種滅菌 ②開啟棉塞 ③管口滅菌 ④挑起菌苔 ⑤接種 ⑥塞好棉塞。
分離純化
含有一種以上的微生物培養物稱為混和培養物(mixed culture)。如果在一個菌落中所有細胞均來自于一個親代細胞,那么這個菌落稱為純培養(pureculture)。在進行菌種鑒定時,所用的微生物一般均要求為純的培養物。得到純培養的過程稱為分離純化,方法有許多種。
1、傾注平板法
首先把微生物懸液通過一系列稀釋,取一定量的稀釋液與熔化好的保持在40-50°左右的營養瓊脂培養基充分混合,然后把這混合液傾注到無菌的培養皿中,待凝固之后,把這平板倒置在恒箱中培養。單一細胞經過多次增殖后形成一個菌落,取單個菌落制成懸液,重復上述步驟數次,便可得到純培養物。

2、涂布平板法
首先把微生物懸液通過適當的稀釋,取一定量的稀釋液放在無菌的已經凝固的營養瓊脂平板上,然后用無菌的玻璃刮刀把稀釋液均勻地涂布在培養基表面上,經恒溫培養便可以得到單個菌落。

3、平板劃線法
最簡單的分離微生物的方法是平板劃線法。用無菌的接種環取培養物少許在平板上進行劃線。劃線的方法很多,常見的比較容易出現單個菌落的劃線方法有斜線法、曲線法、方格法、放射法、四格法等。當接種環在培養基表面上往后移動時,接種環上的菌液逐漸稀釋,最后在所劃的線上分散著單個細胞,經培養,每一個細胞長成一個菌落。

4、富集培養法
富集培養法的方法和原理非常簡單。我們可以創造一些條件只讓所需的微生物生長,在這些條件下,所需要的微生物能有效地與其他微生物進行競爭,在生長能力方面遠遠超過其他微生物。如果要分離一些專性寄生菌,就必須把樣品接種到相應敏感宿主細胞群體中,使其大量生長。通過多次重復移種便可以得到純的寄生菌。
5、厭氧法
在實驗室中,為了分離某些厭氧菌,可以利用裝有原培養基的試管作為培養容器,把這支試管放在沸水浴中加熱數分鐘,以便逐出培養基中的溶解氧。然后快速冷卻,并進行接種。接種后,加入無菌的石蠟于培養基表面,使培養基與空氣隔絕。另一種方法是,在接種后,利用N2或CO2取代培養基中的氣體,然后在火焰上把試管口密封。有時為了更有效地分離某些厭氧菌,可以把所分離的樣品接種于培養基上,然后再把培養皿放在完全密封的厭氧培養裝置中。
6、單細胞(或單孢子)分離法
是采取顯微分離法從混雜群體中直接分離單個細胞或單個個體進行培養以獲得純培養。較大的微生物,可采用毛細管提取單個個體。個體相對較小的微生物,需采用顯微操作儀,在顯微鏡下用毛細管或顯微針、鉤、環等挑取單個微生物細胞或孢子以獲得純培養。單細胞分離法對操作技術有比較高的要求。
培 養
1、根據培養時是否需要氧氣,可分為好氧培養和厭氧培養兩大類。
好氧培養:也稱“好氣培養”。就是說這種微生物在培養時,需要有氧氣加入,否則就不能生長良好。在實驗室中,斜面培養是通過棉花塞從外界獲得無菌的空氣。三角燒瓶液體培養多數是通過搖床振蕩,使外界的空氣源源不斷地進入瓶中。
厭氧培養:也稱“厭氣培養”。這類微生物在培養時,不需要氧氣參加。在厭氧微生物的培養過程中,最重要的一點就是要除去培養基中的氧氣。
2、根據培養基的物理狀態,可分為固體培養和液體培養兩大類。
固質培養:是將菌種接至疏松而富有營養的固體培養基中,在合適的條件下進行微生物培養的方法。
液體培養:在實驗中,通過液體培養可以使微生物迅速繁殖,獲得大量的培養物,在一定條件下,還是微生物選擇增菌的有效方法。
常規鑒定技術

一、形態結構和培養特性觀察
1.微生物的形態結構觀察主要是通過染色,在顯微鏡下對其形狀、大小、排列方式、細胞結構(包括細胞壁、細胞膜、細胞核、鞭毛、芽孢等)及染色特性進行觀察,直觀地了解細菌在形態結構上特性,根據不同微生物在形態結構上的不同達到區別、鑒定微生物的目的。
2.細菌細胞在固體培養基表面形成的細胞群體叫菌落(colony)。不同微生物在某種培養基中生長繁殖,所形成的菌落特征有很大差異,而同一種的細菌在一定條件下,培養特征卻有一定穩定性。以此可以對不同微生物加以區別鑒定。因此,微生物培養特性的觀察也是微生物檢驗鑒別中的一項重要內容。
二、生理生化試驗
微生物生化反應:指用化學反應來測定微生物的代謝產物,生化反應常用來鑒別一些在形態和其它方面不易區別的微生物。因此微生物生化反應是微生物分類鑒定中的重要依據之一。
微生物檢驗中常用的生化反應有:
1、糖酵解試驗
不同微生物分解利用糖類的能力有很大差異,或能利用或不能利用,能利用者,或產氣或不產氣。可用指示劑及發酵管檢驗。
2、淀粉水解試驗
某些細菌可以產生分解淀粉的酶,把淀粉水解為麥芽糖或葡萄糖。淀粉水解后,遇碘不再變藍色。
3、v-p試驗
某些細菌在葡萄糖蛋白胨水培養基中能分解葡萄糖產生丙酮酸,丙酮酸縮合,脫羧成乙酰甲基甲醇,后者在強堿環境下,被空氣中氧氧化為二乙酰,二乙酰與蛋白胨中的胍基生成紅色化合物,稱v-p(+)反應。
4、甲基紅(methyl red)試驗
腸桿菌科各菌屬都能發酵葡萄糖,在分解葡萄糖過程中產生丙酮酸,進一步分解中,由于糖代謝的途徑不同,可產生乳酸,琥珀酸、醋酸和甲酸等大量酸性產物,可使培養基ph值下降至ph4.5以下,使甲基紅指示劑變紅。
5、靛基質(imdole)試驗
某些細菌能分解蛋白胨中的色氨酸,生成吲哚。吲哚的存在可用顯色反應表現出來。吲哚與對二甲基氨基苯醛結合,形成玫瑰吲哚,為紅色化合物。
6、硝酸鹽(nitrate)還原試驗
有些細菌具有還原硝酸鹽的能力,可將硝酸鹽還原為亞硝酸鹽、氨或氮氣等。亞硝酸鹽的存在可用硝酸試劑檢驗。
7、明膠(gelatin)液化試驗
有些細菌具有明膠酶(亦稱類蛋白水解酶),能將明膠先水解為多肽,又進一步水解為氨基酸,失去凝膠性質而液化。
8、尿素酶(urease)試驗
有些細菌能產生尿素酶,將尿素分解、產生2個分子的氨,使培養基變為堿性,酚紅呈粉紅色。尿素酶不是誘導酶,因為不論底物尿素是否存在,細菌均能合成此酶。其活性最適ph為7.0。
9、氧化酶(oxidase)試驗
氧化酶亦即細胞色素氧化酶,為細胞色素呼吸酶系統的終末呼吸酶,氧化酶先使細胞色素c氧化,然后此氧化型細胞色素c再使對苯二胺氧化,產生顏色反應。
10、硫化氫(H2S)試驗
有些細菌可分解培養基中含硫氨基酸或含硫化合物,而產生硫化氫氣體,硫化氫遇鉛鹽或低鐵鹽可生成黑色沉淀物。
11、三糖鐵(TSI)瓊脂試驗
12、硫化氫-靛基質-動力(sim)瓊脂試驗
三、化學成分分析

微生物保存
基本原理是在挑選優良純培養物并使其處于休眠狀態基礎上,人為地創造一個有利于休眠的環境,使其長期保存后仍能保持菌種原有的優良特性。基本措施是低溫、真空、干燥。
保藏方法:
1、定期移植法
亦稱傳代培養保藏法,指將菌種接種于適宜的斜面培養基上,最適條件下培養,完成培養于4-6℃進行保存并間隔一定時間(3-6個月)進行移植培養的一種短期菌種保藏方法。
2、液體石蠟法
指將菌種接種在適宜的斜面培養基上,最適條件下培養好后注入滅菌的液體石蠟,使其覆蓋整個斜面,再直立放置于低溫(4-6℃)干燥處進行保存的一種菌種保藏方法。
3、真空冷凍干燥法
指將保藏的菌種細胞或孢子懸浮于保護劑中,經預凍后在真空條件下使水分升華,再經真空封存后保存的一種長期菌種保存方法。
4、-80℃低溫凍結法
將菌種懸浮于保護劑中,在-80℃冰箱中凍結保存的一種長期菌種保藏方法。

5、液氮超低溫凍結法
指懸浮于保護劑中的菌種經程控降溫后,移置于-196℃的液氮或-150℃左右的液氮氣相中保存的一種長期菌種保藏方法。

來源:Internet


